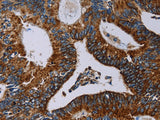
NDUFA4 Polyclonal Antibody Store at -20°C

NDUFA4 Polyclonal Antibody Store at -20°C
SKU: E-AB-13441-200
NDUFA4 Polyclonal Antibody Store at -20°C
| SKU # | E-AB-13441 |
| Reactivity | Human, Mouse |
| Host | Rabbit |
| Applications | WB, IHC |
Product Details
| Isotype | IgG |
| Host | Rabbit |
| Reactivity | Human, Mouse |
| Applications | WB, IHC |
| Clonality | Polyclonal |
| Immunogen | Synthetic peptide of human NDUFA4 |
| Abbre | NDUFA4 |
| Synonyms | CI 9k, CI-MLRQ, Complex I 9kDa subunit, Complex I-MLRQ, MLRQ, NADH dehydrogenase (ubiquinone) 1 alpha subcomplex 4 9kD, NADH dehydrogenase [ubiquinone] 1 alpha subcomplex subunit 4, NADH-ubiquinone oxidoreductase MLRQ subunit, NDUA4, NDUFA4 |
| Swissprot | |
| Calculated MW | 9 kDa |
| Cellular Localization | Mitochondrion inner membrane. |
| Concentration | 0.7 mg/mL |
| Buffer | Phosphate buffered solution, pH 7.4, containing 0.05% stabilizer and 50% glycerol. |
| Purification Method | Affinity purification |
| Research Areas | Metabolism, Signal Transduction |
| Conjugation | Unconjugated |
| Storage | Store at -20°C Valid for 12 months. Avoid freeze / thaw cycles. |
| Shipping | The product is shipped with ice pack, upon receipt, store it immediately at the temperature recommended. |
Related Reagents
| Applications | Recommended Dilution |
| WB | 1:500-1:2000 |
| IHC | 1:50-1:200 |
Background
The protein encoded by this gene belongs to the complex I 9kDa subunit family. Mammalian complex I of mitochondrial respiratory chain is composed of 45 different subunits. This protein has NADH dehydrogenase activity and oxidoreductase activity. It transfers electrons from NADH to the respiratory chain. The immediate electron acceptor for the enzyme is believed to be ubiquinone.